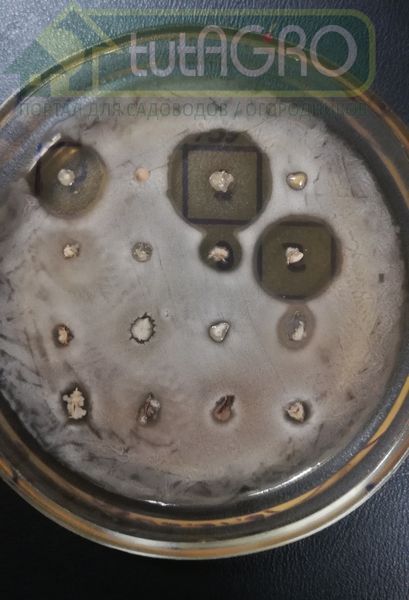

Среди множества различных патогенных для растений микроорганизмов бактерии являются наиболее вредоносными. В последние годы бактериозы заняли лидирующие позиции в качестве виновников потерь урожая, причем, как в поле, так и при хранении.
И это при том, что повсеместно используется широкий арсенал различных фунгицидов против болезней растений. А дело в том, что даже самые «тяжелые» химически синтезированные препараты от грибных болезней… не эффективны против бактерий!
Убивая разнообразные грибы, особенно при бесконтрольном применении химически синтезированных препаратов, мы освобождаем «нишу» для бактерий, причем, вредных, которые вызывают и сосудистые увядания, и пятнистости, и гнили.
Среди вредоносных бактерий одной из самых «злых» является пектобактерия-морквоед (Pectobacterium carotovorum), которая
- является основной причиной возникновения черной ножки у рассады томата (а также у картофеля и др.), особенно после первой пикировки,
- вызывает увядание и гниль у огурца, томата, баклажана, перца, слизистую и мокрую гнили у капуст: пекинской, кочанной, цветной и др.,
- поражает корнеплоды: свеклу, морковь, редис и редьку,
- вызывает гнили у зеленных растений (салата, петрушки, укропа, шпината, мангольда и др.), а также орхидей и сенполий.
Она способна поражать буквально все растения и заселяться в любые части растения - в плоды, корни, стебли, листья…
Разумеется, ученые ищут способы победить эту напасть. На помощь приходит известная многим садоводам и огородникам сенная палочка. Но, как мы не раз отмечали, сенные палочки бывают разные. Как разные сорта томатов отличаются друг от друга, так и сенная палочка из разных препаратов на ее основе отличается спектром и силой своей активности. А препаратов немало: Бактоген, Бактофит, Алирин, Гамаир, Фитоспорин и многие другие.
Какие же из множества препаратов являются наиболее активными в отношении пектобактерии?

По результатам (см. фото) проведенных микробиологических испытаний (чем больше зона отсутствия роста бактерий (ореол), тем эффективнее препарат: 2 - новый перспективный штамм - основа будущего биопрепарата, 3 - Бактофит, 4 - Бактоген, 5 - Гамаир, 6 - Фитоспорин) видно, что препараты Бактоген (4) и Гамаир (5) - самые мощные защитники растений от пектобактерий. Кроме того, они подавляют рост и других вредных бактерий: эрвиний, псевдомонад и клавибактера, которые также могут наделать много бед и в огороде, и в саду. Одновременно сенная палочка из этих препаратов активно борется с самыми трудно искоренимыми вредными грибами - возбудителями фузариоза, вертициллеза, кладоспориоза и др.
Применять Бактоген и Гамаир лучше в смеси - так эффективность против болезней повышается в несколько раз. Начинать бороться с опасными болезнями растений с помощью этих препаратов надо с самого начала - проливать почву для рассады, замачивать семена, луковицы, саженцы, клубни и т.д. в растворах, приготовленных по инструкции, поливать и опрыскивать растения в процессе роста и развития хотя бы 1 раз в 10-12 дней.
Препараты не опасны для человека и животных, поэтому растворами можно обрабатывать все растения в любой период, даже капусту, собирающуюся в кочан. И не только в поле или теплице, но и при закладке на хранение.
При самостоятельном выращивании препаратов в домашних условиях можно получать их совершенно бесплатно хоть ведрами! Поэтому применение биопрепаратов не только эффективно, но и очень выгодно.
Автор Иван РУССКИХ














